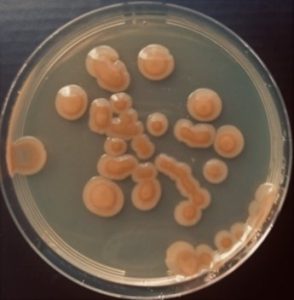
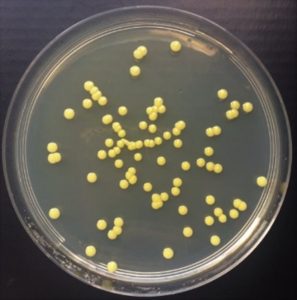
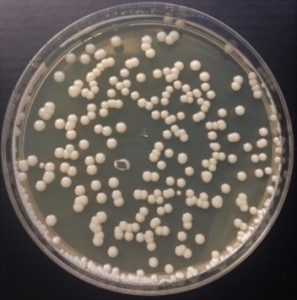

Į aplinką patekusios cheminės medžiagos galiausiai pasiekia vandens telkinius, todėl ekotoksikologijoje didelis dėmesys skiriamas poveikio įvairiems vandens organizmams tyrimams. Tyrimuose stengiamasi įvertinti toksinų poveikį visoms ekosistemoms dalims, todėl tiriamas poveikis įvairių trofinių lygių organizmams.
Susipažinkite su pagrindinėmis tiriamomis organizmų grupėmis.
Bakterijos
![]() |
![]() |
![]() |
| Bakterijos iš margojo upėtakio žarnyno | ||
Vandens dumbliai ir augalai (menturdumbliai, plūdenos)
![]() |
![]() |
![]() |
![]() |
| Žalieji dumbliai (Desmodesmus communis) |
Titnagdumbliai (Achnanthes lanceolata var. rostrata) |
Menturdumbliai (Metalepsis obtuse) |
Plūdenos (Lemna minor) |
Vėžiagyviai (ostrakodai, dafnijos, krabai)
![]() |
![]() |
![]() |
![]() |
| Cereodaphnia dubia | Cereodaphnia dubia – nėščia | Daphnia magna | Thamnocephalus platyrus |
![]() |
| Eksperimentai su dumbliniais krabais (Rhithropanopeus harrisii) |
Ostrakodas (Heterocypris incongruens)
Jūriniai ir gėlavandeniai moliuskai (geldutės, midijos)
![]() |
| Geldutės (Unio spp.) |
Jūrinės ir gėlavandenės žuvys (lašišos, upėtakiai, menkės, plekšnės, danijos)
![]() |
![]() |
| Lašiša (Salmo salar) | Zebrinė danija (Danio rerio) |
![]() |
![]() |
| Plekšnės ir oto jaunikliai | Šlakių ankstyvos stadijos – ikras ir lervos |
Dėl svetainės pritaikymo neįgaliesiems
PROGRAMĖLĖS KŪRĖJŲ ŽODIS
Atitikties statusas
Mes esame įsitikinę, kad naudojimasis internetu turėtų būti prieinamas visiems, todėl nuosekliai siekiame, kad svetainėmis galėtų naudotis plačiausia galima auditorija, nepriklausomai nuo aplinkybių ir gebėjimų.
Įgyvendindami šį norą, siekiame kuo griežčiau laikytis pasaulinio žiniatinklio konsorciumo (W3C) turinio prieinamumo gairių 2.1 (WCAG 2.1) AA lygiu. Šios gairės nurodo, kaip žiniatinklio turinį galima padaryti prieinamą žmonėms su įvairaus pobūdžio negalia. Atitiktis šioms gairėms padeda užtikrinti, kad puslapis prieinamas visiems: akliesiems, žmonėms su judėjimo, regos, pažintinių funkcijų ir kitais sutrikimais.
Šioje svetainėje naudojamos įvairios technologijos, skirtos ją padaryti kuo prieinamesnę bet kuriuo metu. Naudojame prieinamumo sąsają, leidžiančią asmenims su specifine negalia pritaikyti svetainės UI (naudotojo sąsają) ir dizainą prie savo asmeninių poreikių.
Be to, svetainėje naudojama AI paremta funkcija, kuri nuolat optimizuoja svetainės pritaikymo lygį. Ši funkcija atkuria svetainės HTML, pritaiko jos funkcijas ir veikimą ekranų skaitytuvams, kuriuos naudoja aklieji, ir klaviatūros funkcijas, naudojamas žmonių su judėjimo sutrikimais.
Jei pastebėjote gedimų ar turite funkcijų pagerinimo idėjų, mielai su jomis susipažinsime.
Ekrano skaitytuvai ir valdymas klaviatūra
Interneto svetainėje įdiegta ARIA atributų (angl. Accessible Rich Internet Applications) technologija, kad užtikrintume, jog akli naudotojai, besinaudojantys ekranų skaitytuvais, galėtų skaityti svetainės tekstus ir naudotis jos funkcijomis. Kai tik naudotojas su ekrano skaitytuvu patenka į svetainę, jis tuoj pat gauna priminimą įsijungti Aklumo režimo profilį, kad galėtų efektyviai naršyti ir naudotis svetaine. Apačioje pateikiame informaciją, kaip mūsų svetainėje užtikrinamos kai kurios svarbios ekranų skaitytuvų funkcijos:
Vartotojai taip pat gali naudoti sparčiuosius klavišus, tokius kaip „M“ (meniu), „H“ (antraštės), „F“ (formos), „B“ (mygtukai) ir „G“ (grafika), norėdami pereiti į specifinius elementus.
Šioje svetainėje palaikomi režimai
Papildomas UI, dizaino ir skaitomumo pritaikymas
Naršyklės ir pagalbinės technologijos suderinamumas
Programėlė suderinama su įvairiausiomis naršyklėmis, kad naudotojai galėtų rinktis tai, kas jiems priimtiniausia. Įdėjome daug pastangų, kad programėlė būtų palaikoma pagrindinių sistemų, kurios sudaro 95 % rinkos, įskaitant Google Chrome, Mozilla Firefox, Apple Safari, Opera, Microsoft Edge, JAWS, NVDA (ekrano skaitytuvai), tiek Windows, tiek MAC naudotojams.
Pastabos ir komentarai
Nepaisant mūsų dėtų pastangų leisti lankytojams prisitaikyti šią svetainę pagal savo poreikius, vis tiek gali būti puslapių ar svetainės dalių, kurios nėra iki galo pritaikytos, kurias šiuo metu bandome pritaikyti ar joms dar neturime tinkamo techninio sprendimo. Nuolat geriname svetainės prieinamumą pridėdami ar atnaujindami įvairias funkcijas ir vystydami bei pritaikydami įvairias technologijas. Tai darome tam, kad skirtingų poreikių naudotojai galėtų optimaliai naudotis svetaine ir jos pritaikymas žengtų koja kojon su technologine pažanga.